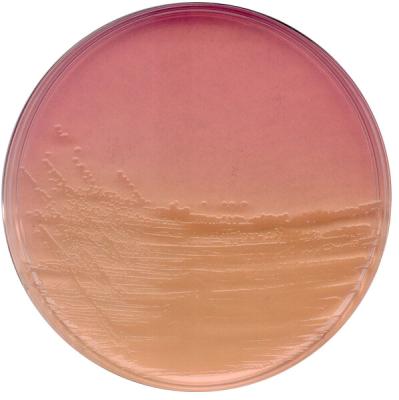
Эндо агар для микробиологии 1040440500

Эндо агар для микробиологии
Артикул:
1040440500
ENDO agar for microbiology
Подробнее
Запросить стоимость
Описание
Селективная питательная среда для выявления Е.coli и колиформных бактерий из различных материалов по методу ЭндоХарактеристики
|
Упаковка
|
500 г |